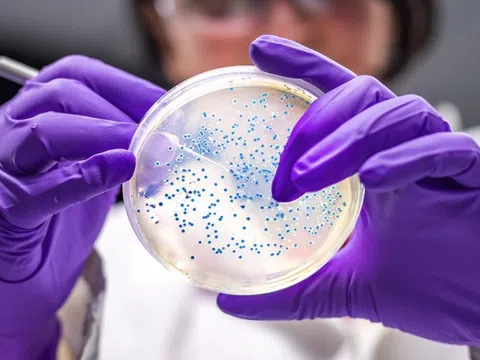
Công bố 29 siêu vi khuẩn nguy hiểm nhất với con người

Trẻ sơ sinh có răng mọc ngay lúc sinh, hiện tượng hiếm gặp hay kỳ lạ?
Thông thường, răng cửa sữa hàm dưới mọc đầu tiên vào lúc khoảng 6 tháng tuổi. Tuy nhiên trong một số ít trường hợp, trẻ sơ sinh khi vừa chào đời đã có răng hoặc có răng mọc ngay trong tháng đầu tiên.
Máy hỏng, bệnh viện vẫn kê khai hàng trăm ca sử dụng: Bộ Y tế nói gì?
12:01 19/09/2025
Theo Bộ Y tế, đây là sự việc nghiêm trọng, có thể trực tiếp ảnh hưởng đến sức khỏe người bệnh, gây mất niềm...
Các bệnh viện chạy đua áp dụng bệnh án điện tử
12:01 19/09/2025
Tại TP.HCM, các bệnh viện đang chạy đua thời gian để bệnh án điện tử cán đích trước ngày 30-9. Bên cạnh những bệnh...
Bác sĩ mổ khẩn, cứu bệnh nhân người Nga không tiền, không người thân
12:01 19/09/2025
Người đàn ông quốc tịch Nga nhập viện trong tình trạng nguy kịch vì thủng tạng rỗng. Các bác sĩ đã kịp thời phẫu...
Tình hình các nạn nhân vụ tai nạn thương tâm ở chợ Tân Long
12:01 19/09/2025
Các nạn nhân nhập viện Bệnh viện Đa khoa tỉnh Quảng Trị trong tình trạng đa chấn thương nghiêm trọng ở sọ não, cột...
4 kiểu ngủ phổ biến tiết lộ nguy cơ mắc bệnh mạn tính
12:00 19/09/2025
Mỗi kiểu ngủ đều có những tác động tới sức khỏe mà nếu bạn duy trì sai cách, chúng có thể trở thành “cửa...
Tin tức sáng 19-9: TP.HCM đề xuất đầu tư 100 dự án y tế; Hà Nội nghi có rau 'lạ' vào trường học
12:00 19/09/2025
Tin tức đáng chú ý: TP.HCM đề xuất 66.000 tỉ cho 100 dự án y tế giai đoạn năm 2026 - 2030; Hà Nội...
Mắc ung thư đại trực tràng ở tuổi 25
12:00 19/09/2025
Những cơn rối loạn tiêu hóa âm thầm suốt 4 năm, đến khi đau bụng dữ dội nhập viện, Xuân Quang sốc khi biết...
Vinmec gây ấn tượng với robot y tế 'Make in Vietnam'
00:01 19/09/2025
Tại Triển lãm “Những thành tựu nổi bật trong ngành y tế và giáo dục”, Hệ thống Y tế Vinmec đã giới thiệu loạt...
Mất ngủ do gan nóng, ăn 4 món canh này để ngủ sâu hơn
00:00 19/09/2025
Nếu bạn thường xuyên trằn trọc khó ngủ do gan nóng, hãy thử nấu và thưởng thức những món canh giúp giải độc gan,...
Nguyên nhân khiến trẻ bị còi xương
00:00 19/09/2025
Còi xương có thể gây trở ngại cho sự phát triển toàn diện của trẻ, bao gồm cả khía cạnh về thể chất và...
Máy hỏng, bệnh viện vẫn kê khai tán sỏi cho 255 bệnh nhân
00:00 19/09/2025
Máy tán sỏi laser tại Bệnh viện Đa khoa vùng Tây Nguyên bị hỏng nhưng vẫn kê khai thực hiện tán sỏi cho ít...
Dấu hiệu vết thương hở có thể bị nhiễm trùng
00:00 19/09/2025
Nếu bị chấn thương và có dấu hiệu đỏ kéo dài, sưng tấy hoặc chảy mủ có mùi hôi, đây là những dấu hiệu...
Ăn cà rốt thường xuyên có ngừa được bệnh tim?
00:00 19/09/2025
Dù giàu dưỡng chất tốt cho tim mạch, cà rốt không phải "thần dược" phòng bệnh tim như một số bài đăng trên mạng...
Tin đọc nhiều
Nguyên nhân, triệu chứng, phòng bệnh viêm đài bể thận
Top 3 Xưởng đúc đồ thờ cúng bằng đồng uy tín nhất Nam Định
Pharmacity hỗ trợ tầm soát miễn phí hen phế quản và COPD
Một bộ phận của ốc tuyệt đối không nên ăn
Angelina Jolie thu hút khi đeo trâm cài ở Venice
Mỗi phút tiếp xúc ánh sáng xanh phá hủy hàng triệu tế bào nhãn cầu
Măng tây có giá trị dinh dưỡng nhiều đến mức nào?
Dấu hiệu sớm của ung thư ruột non
Đang làm rõ ca tử vong sau thay van động mạch chủ qua da liên quan bác sĩ Bệnh viện Bạch Mai
Thị trấn ở nơi tận cùng thế giới
Việt Nam là 'điểm nóng' sốt xuất huyết, cần có chiến lược ứng phó chủ động
Phát hiện 1 phòng khám chưa có giấy phép đã 3 lần đổi tên, loại hình kinh doanh
Biến chứng nguy hiểm khi chích silicon làm to 'cậu nhỏ'
Đường lây của bệnh bạch hầu
Chế tạo vaccine 'đón đầu' mọi chủng virus Corona
Thám hiểm lòng hố sụt trong công viên địa chất Non Nước
Tức giận và thức khuya làm hại gan ra sao?
Bố mẹ thấp nhưng con cao lớn nhờ điều này

Hà Nội: Mãn nhãn sân chơi Cây cảnh nghệ thuật triệu đô tại Ninh Hiệp
18:00 21/02/2023

Trải nghiệm “văn hoá lẩu” độc đáo tại xứ Đài
08:49 24/12/2024

Chương trình nghệ thuật “Hương Sắc Thủ Đô 2024”
14:40 09/12/2024

Cách phối dép lê trông sang ngày hè
01:00 10/07/2025

Trang phục đơn sắc của 'Mỹ nhân cười đẹp nhất Hàn Quốc'
01:00 10/07/2025

Tiệm bánh mì hấp lưu giữ hương vị một thời Sài Gòn
01:00 10/07/2025

Công viên nước Hà Nam ưu đãi combo vé và ẩm thực cho du khách
01:00 10/07/2025

Những điểm nên đến bên ngoài TP Huế
01:00 10/07/2025

Khách Việt đang đi đâu nhiều nhất tại châu Á?
01:00 10/07/2025

NMN Premium - hỗ trợ tăng sức đề kháng, cải thiện lão hoá da
12:00 20/11/2025

Giới trẻ truyền tai nhau về DIINBI, trend chăm sóc da mới là đây?
18:00 18/11/2025

Bỏng đầu khi uốn tóc
18:00 08/11/2025